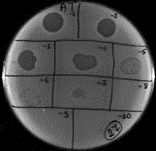
foto Czy bakteriofagi mogą pom&oacute;c w walce przeciwko wzrastającej oporności bakterii na antybiotyki?

Informator uniwersytecki
Szanowni Państwo!
Czeka nas rok niezwykły, ponieważ w 2025 roku czeka nas kilka ważnych jubileuszy – w tym najważniejszy 75 lat Uniwersytetu Medycznego w Lublinie. Przygotowaliśmy kalendarz obchodów wypełniony po brzegi wydarzeniami. Jubileusz to czas podsumowań, ale także czas, aby docenić zasługi osób, które pracowały przez lata na sukcesy jednostek. Będziemy źródłem informacji, ale także miejscem podsumowań i relacji z wydarzeń. Zachęcamy do dzielenia się z nami wspomnieniami, zdjęciami, sukcesami, tymi poważnymi, tymi na wesoło, tymi wzruszającymi.
Adres blask@umlub.pl jest dla Was. Chcemy, aby ten rok był wyjątkowy.
Drodzy studenci, przed Wami czas sesji zaliczeniowo-egzaminacyjnej, uczcie się i zdawajcie egzaminy na piątki, a nawet piątki z plusem. Życzymy, aby wysiłek włożony w naukę, zaprocentował ocenami na egzaminach.
Powodzenia!

Lubelska Transplantologia 2025
Jeden potencjalny dawca może uratować 8 osób, a w przypadku tkanek nawet kilkanaście do kilkudziesięciu. Rozwój dawstwa jest istotny, bo cząstka tej osoby żyje później przez wiele lat w kimś innym – dr Teresa Danek, Poltransplant

Biuro Prasowe Uniwersytetu Medycznego w Lublinie i Szpitali Klinicznych
"Tworzymy wspólne Biuro Prasowe, aby podkreślić potencjał naukowy, badawczy i dydaktyczny, którym dysponujemy" – prof. Kamil Torres

Prof. Artur Czekierdowski współautorem publikacji w Nature Medicine
Prof. Artur Czekierdowski z I Katedry i Kliniki Ginekologii Onkologicznej i Ginekologii współautorem publikacji w Nature Medicine

Briefing prasowy w USK1: sztuczna inteligencja pomocna w lepszym diagnozowaniu raka jajnika
O innowacyjnych metodach diagnostycznych w praktyce klinicznej leczenia nowotwrów jajnika.

60 lat w służbie pacjentom – jubileusz USK4
27 stycznia 2025 roku odbyła się jubileuszowa uroczystość, podczas której nastąpiło wręczenie medali i odznaczeń państwowych osobom zasłużonym jednostce oraz pracownikom, których działalność przyczyniła się do podniesienia jakości opieki zdrowotnej w województwie lubelskim.

OSCE, OSCE i jeszcze raz OSCE…
Pracownicy Uniwersytetu Medycznego w Białymstoku i Śląskiego Uniwersytetu Medycznego z wizytą stażową na Wydziale Lekarsko-Dentystycznym

Program szkoleń z zakresu nowoczesnej endodoncji – 3 lata współpracy z firmą Poldent
Współpraca nauki, edukacji i biznesu!

Stypendia dla zdolnych badaczek
Trwa nabór do 25. edycji programu L’Oréal-UNESCO Dla Kobiet i Nauki

Zła organizacja prowadzi do błędów
Stwierdzenie, że błąd w udzielaniu świadczeń medycznych był wynikiem złej organizacji nie uwalnia od odpowiedzialności medyków, którzy zajmowali się pacjentem.

Koncert "Dajmy radość chorym dzieciom"
Koncert zapoczątkował wielkie przedsięwzięcie, jakim jest utworzenie zewnętrznego placu zabaw przy USzD.

Szpitale uniwersyteckie łączą siły w walce nowotworami
"Choć leczymy skuteczniej, pacjentów przybywa, co bardzo nas niepokoi” – mówi dr hab. Marek Sawicki, prof. uczelni, Prorektor ds. Klinicznych.

Welcome to Las Vegas part 2: The card games
How the evaluating system for academics has degenerated into a travesty similar to gambling in Las Vegas.

Doustne diety przemysłowe w leczeniu żywieniowym
Doustne diety przemysłowe stanowią nieocenione wsparcie w leczeniu niedożywienia oraz w leczeniu żywieniowym pacjentów w różnych stanach klinicznych.

#4 Jak zaprzyjaźnić się z porażką?
Słowa kształtują naszą rzeczywistość – zamiast mówić „przegrałem”, warto powiedzieć „dowiedziałem się, co mogę zrobić lepiej następnym razem”.

Detoks napięcia i emocji w gabinecie kosmetologicznym
Kosmetologia zajmuje się szeroko pojętymi działaniami na rzecz dobrego wyglądu i samopoczucia człowieka - dobry wygląd łączy się z dobrym zdrowiem.

W Bibliotece już wiedzą, co będzie na egzaminie
Sesja?! Szanse na powodzenie zwiększa wizyta w Bibliotece Głównej przy ulicy Szkolnej 18, gdzie można skorzystać z książek na miejscu lub wypożyczyć je do domu, ale także wizyta w czytelni w budynku Centrum Symulacji Medycznej.

Curie-Musk conversation…
Elon Musk: Excuse me, are you... Marie Curie? Two Nobel Prizes, pioneer of radioactivity, literal glowing personality?
Maria Skłodowska-Curie: Indeed. And you must be... the man trying to turn the entire planet into a test track for self-driving cars?



Gala konkursu "Orły Nauki"
IV Gala "Orłów Nauki" za nami, zapraszamy do zapoznania się z wynikami.

Erasmus+ także dla absolwentów
Program Erasmus+ daje wiele możliwości, wyjazdy w ramach programu są możliwe także już po uzyskaniu statusu absolwenta uczelni, jako tzw. recent graduate.

Lublin International Students’ Surgical Congress 2025
III edycja międzynarodowej konferencji naukowo-szkoleniowej dla studentów i młodych lekarzy odbędzie się w dniach od 3 do 5 kwietnia 2025 r. Zapraszamy wszystkich zainteresowanych.

Grudzień w PTSF
Koniec roku to gorący czas w SKNach i organizacjach studenckich. Zapraszamy do przeczytania, jakie wydarzenia odbywały się w PTSF Lublin.

Nasi dziekani – prof. dr. hab. Beata Dobrowolska
"Zależy nam na stworzeniu na tyle atrakcyjnej oferty kształcenia w Szkole Doktorskiej oraz dopracowaniu kryteriów rekrutacji, aby przyciągnąć najlepszych kandydatów, reprezentujących dyscypliny nauk medycznych, nauk farmaceutycznych i nauk o zdrowiu.

Rola białek (w szczególności transporterów ABC) w regulacji składu i struktury błony komórkowej
W pracy doktorskiej skupiłam się na roli białek (w szczególności transporterów ABC) w regulacji składu i struktury błony komórkowej w procesie nowotworzenia.

Skuteczna terapia ukierunkowana na zmniejszenie dolegliwości bólowych
Koncentruję się na planowaniu skutecznej terapii ukierunkowanej na zmniejszenie dolegliwości bólowych u pacjentów z mięśniowo-powięziowymi zaburzeniami stawów skroniowo-żuchwowych.

O izolacji związków fenolowych zawartych w wyciągach Zingiber officinale
Projekt koncentruje się na opracowaniu optymalnych warunków analitycznych do izolacji aktywnych związków fenolowych z kłączy imbiru lekarskiego



Programy profilaktyczne "Postaw na zdrowie"
"Postaw na zdrowie" programy profilaktyczne z zakresu chorób nowotworowych, chorób układu krążenia, chorób metabolicznych, chorób układu nerwowego dla mieszkańców województwa lubelskiego
Czy bakteriofagi mogą pomóc w walce przeciwko wzrastającej oporności bakterii na antybiotyki?
Badania nad bakteriofagami przeżywają dynamiczny rozwój, szczególnie w kontekście ich potencjalnych zastosowań medycznych. Stanowią one obiecującą alternatywę w leczeniu infekcji wywołanych przez bakterie oporne na antybiotyki.

Nowe perspektywy w walce z gruźlicą
Śmiertelność z powodu gruźlicy bez podjęcia leczenia wynosi około 50%. Pandemia Covid-19 nasiliła problem i spowodowała ograniczony dostęp do diagnostyki i leczenia gruźlicy.

Proteomika jako narzędzie weryfikacji składu żywności
Projekt koncentruje się na wykrywaniu i zapobieganiu fałszowaniu żywności poprzez precyzyjne określenie składu białkowego wysoko przetworzonych produktów spożywczych pochodzenia zwierzęcego.

Edukacja w zasięgu ręki - Wykłady dla Społeczeństwa – ciekawe tematy, eksperci i dostępność dla każdego
Program zaprasza mieszkańców Lublina i nie tylko, do bezpłatnej edukacji na tematy dotyczące zdrowia.

Inteligentne biomateriały aktywowane polem magnetycznym oraz zimną plazmą atmosferyczną
Zespół Zakładu Inżynierii Tkankowej i Medycyny Regeneracyjnej UM w Lublinie w ramach dwóch grantów finansowanych przez Narodowe Centrum Nauki (Sonata 19 oraz Opus 27) prowadzi badania mające na celu opracowanie inteligentnych biomateriałów aktywowanych polem magnetycznym lub/i zimną plazmą atmosferyczną do zastosowań w spersonalizowanej medycynie regeneracyjnej.

Współpraca w ramach umowy partnerskiej Go4Cosmetics
Uniwersytet Medyczny w Lublinie nawiązał strategiczną współpracę z europejską międzyregionalną siecią dedykowaną branży kosmetycznej, przystępując do umowy partnerskiej Go4Cosmetics.

Innowacje Uniwersytetu Medycznego w Lublinie: patenty, postęp i współpraca z przedsiębiorcami
Rok 2024 okazał się niezwykle owocny dla Uniwersytetu Medycznego w Lublinie w zakresie innowacji i ochrony własności intelektualnej.

Współpraca nauki z przemysłem na rzecz innowacji w medycynie - na przykładzie współpracy z Medical Inventi
Z biegiem lat współpraca między Uniwersytetem Medycznym w Lublinie a firmą Medical Inventi S.A. znacząco się rozszerzyła, obejmując różnorodne obszary wsparcia badawczo-technologicznego.










